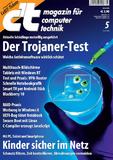

Mobil surfen - der blinde Fleck der Eltern
c't: Kinder sicher im Netz
(PresseBox) - Seit sich mit Smartphones und Tablets vollwertig surfen lässt, ist es für Eltern wesentlich schwieriger geworden, über die Online-Aktivitäten ihrer Kinder zu wachen, weil die kaum noch daheim stattfinden. Mit ein wenig Know-how und der passenden Software können Eltern dennoch ihrer Fürsorgepflicht nachkommen und dem Kind einen sicheren Rahmen fürs Surfen schaffen, schreibt die Computerzeitschrift c't in Ausgabe 5/13.
Apple punktet besonders mit seinem geschlossenen System: Außerhalb von iTunes und dem Apple-Store gelangt das Kind nicht an Inhalte und bewegt sich vergleichsweise sicher. "Seit iOS 6 können Eltern Einschränkungen wie das deutsche FSK-Modell mit Stufen ab 6, 12, 16 und 18 Jahren vorsehen, ohne dass die Kinder ständig Sperrmeldungen erhalten", erklärt c't-Redakteur Jo Bager. Unter Windows Phone 7.5 und 8 gibt es die "Kinderecke". Der Hauptnutzer des Geräts kann über diese Option eine eigene Oberfläche für die Kleinen einrichten. Weniger ausgereift sind die Kinderschutzfunktionen bei Android. Sie können aber mit Hilfe sogenannter Launcher oder filternder Browser wie FragFINN nachgerüstet werden.
Auf dem Heimrechner empfiehlt sich prinzipiell die Installation einer Filtersoftware. Für jüngere Kinder eignen sich Whitelist-Filter, die nur durchlassen, was zuvor als unbedenklich klassifiziert wurde. Bei Jugendlichen, die sich freier bewegen wollen, ist man mit sogenannten Blacklists besser bedient. Sie teilen Webseiten in Kategorien wie Kinderseiten, Hass und Gewalt oder Pornografie ein und sperren böse Inhalte aus. "Bei der Fülle an neuen Angeboten schlüpfen aber immer wieder ungewünschte Seiten durch den Filter", sagt Bager.
Eltern dürfen sich deshalb nie allein auf technische Mittel verlassen. Sie sollten wachsam sein und ein Auge darauf haben, was ihre Kinder im Netz treiben. "Am besten geht man die ersten Schritte im Web gemeinsam mit dem Kind und spricht offen über den Umgang mit Netzinhalten", so der c't-Experte.
Themen in diesem Fachartikel:
Unternehmensinformation / Kurzprofil:
Datum: 08.02.2013 - 11:10 Uhr
Sprache: Deutsch
News-ID 811896
Anzahl Zeichen: 0
Kontakt-Informationen:
Ansprechpartner:
Stadt:
Hannover
Telefon:
Kategorie:
IT, New Media & Software
Anmerkungen:
Dieser Fachartikel wurde bisher 63 mal aufgerufen.
Der Fachartikel mit dem Titel:
"Mobil surfen - der blinde Fleck der Eltern"
steht unter der journalistisch-redaktionellen Verantwortung von
Heise Medien Gruppe GmbH&Co KG (Nachricht senden)
Beachten Sie bitte die weiteren Informationen zum Haftungsauschluß (gemäß TMG - TeleMedianGesetz) und dem Datenschutz (gemäß der DSGVO).




